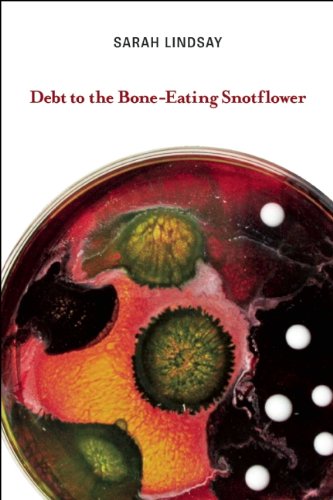
Debt to the Bone-Eating Snotflower by Sarah Lindsay

No discussions yet. Join BookLovers to start a discussion about this book!
No reviews yet. Join BookLovers to write the first review!
No quotes shared yet. Join BookLovers to share your favorite quotes!
Similar Books in All Non-Fiction
View All Similar
Careless People: A Cautionary Tale of Power, Greed, and Lost Idealism

Punderdome: A Card Game for Pun Lovers

18 Days in Heaven: I Left My Body. I Met Jesus. What He Told Me Will Alter Your Eternity.

Becoming a Principle-Driven Leader: 41 Principles to Build an Enduring Business

Taylor Swift: Unofficial Search-and-Find Biographies

Saved by the Pack: How 50 Dogs Helped Me Find My Purpose


